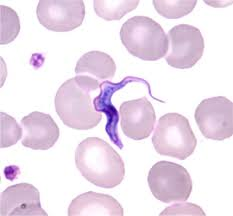
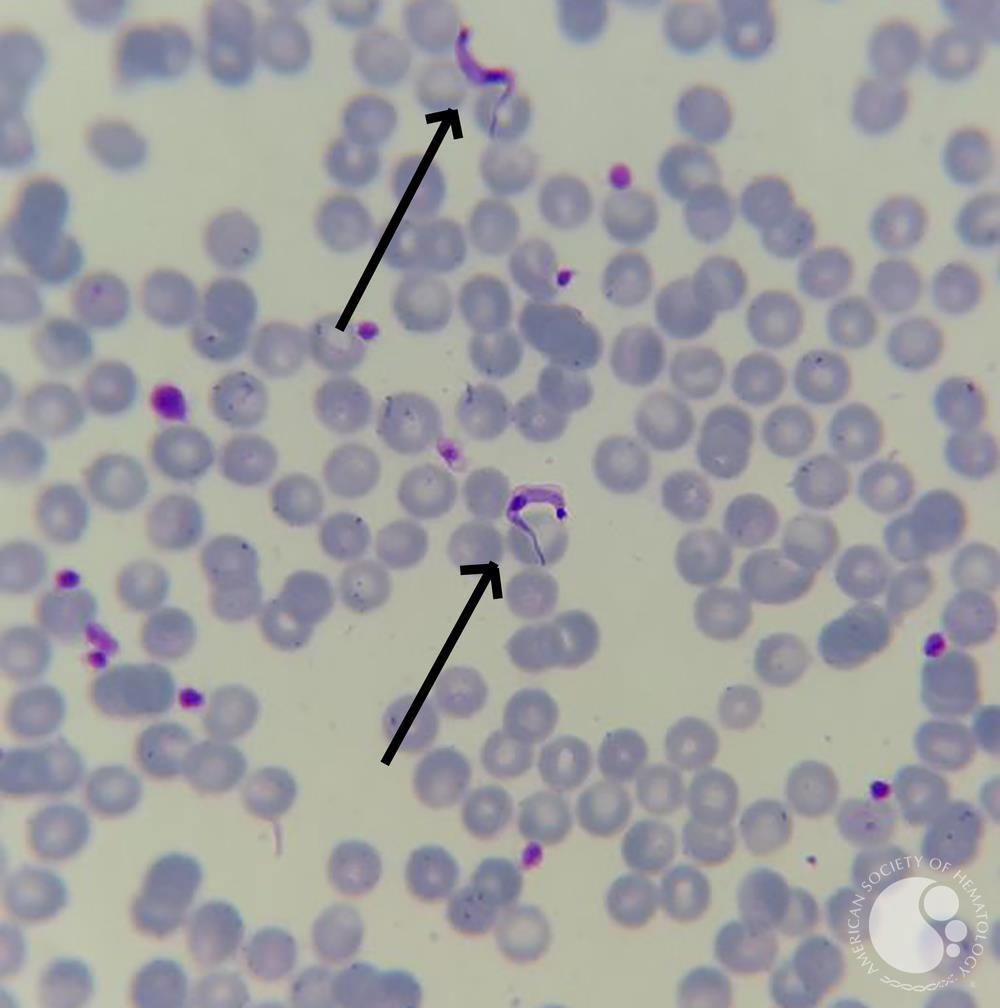
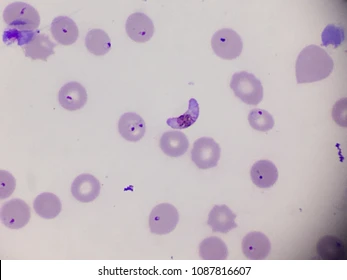
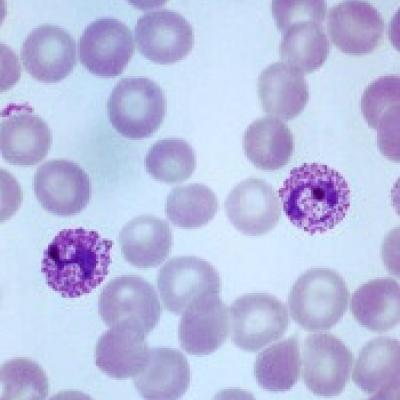
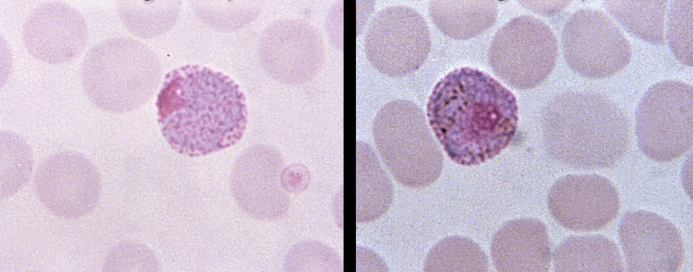
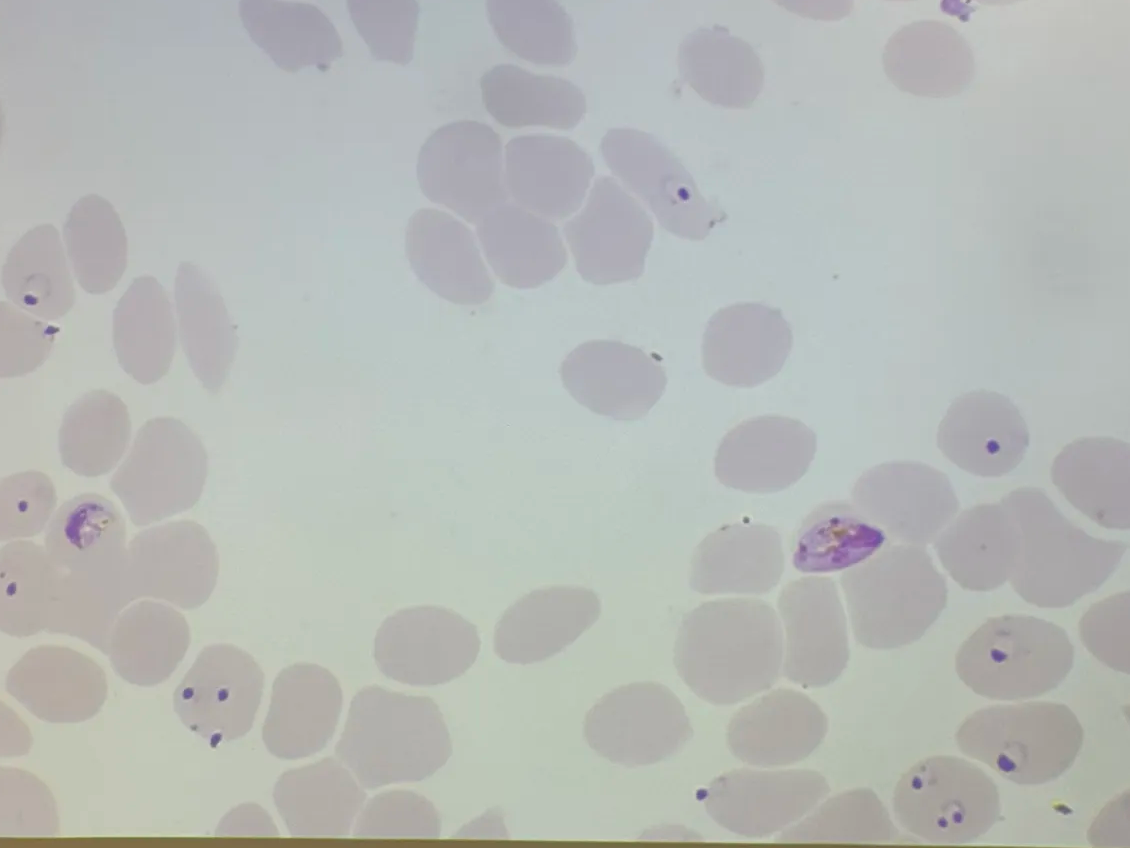
<p>in human blood smear</p>

1/87
Looks like no tags are added yet.
Name | Mastery | Learn | Test | Matching | Spaced | Call with Kai |
|---|
No analytics yet
Send a link to your students to track their progress

in an animal, fever, lethargy
West Africa
Trypanosoma brucei brucei
bloodstream trypomastigote
Nagana
Tse-tse fly

in human or ruminant
fast onset, winterbottom’s sign, personality changes
East Africa
Trypanosoma brucei rhodesience
bloodstream trypomastigote
Acute African Sleeping Sickness
Tse-tse fly
in human
slow onset, winterbottom’s sign, sleep disturbances
West/Central Africa
Trypanosoma brucei gambiense
bloodstream trypomastigote
Chronic African Sleeping Sickness
Tse-tse fly

in human or animal
fatigue
Trypanosoma spp.
amastigote in tissue

in fly
Trypanosoma spp.
epimastigote (1) and metacyclic trypomastigote (2) in tse-tse fly
in humans and pets
Romana’s sign, cardiac failure, nervous dysfunction
Central/South America
Trypanosoma cruzi
bloodstream trypomastigote
Chagas Disease
kissing bug

in fly
Mediterranean sea, east to Russia and China
Leishmania donovani
promastigote in sand fly
Visceral Leishmaniasis

in fly
Mediterranean sea, West and South Asia, Central and NE Africa
Leishmania tropica
promasitgote in sand fly
Cutaneous Leishmaniasis

in human
red papule at bite, warty nodular eruptions
Mediterranean Sea and east to Russia + China, or West and South to Asia, Central Africa, NE Africa
Leishmania spp.
amastigote in tissue
Visceral or Cutaneous Leishmaniasis
sand fly

in human
red papule at bite, warty nodular eruptions
Mediterranean Sea and east to Russia + China, or West and South to Asia, Central Africa, NE Africa
Leishmania spp.
amastigote in tissue
Visceral or Cutaneous Leishmaniasis
sand fly

in fresh human or animal stool
diarrhea, abdomen pain
worldwide
Giardia lamblia
trophozoite in fresh stool
Giardiosis
Fecal/oral transmission

in human or animal stool
diarrhea, abdominal pain
worldwide
Giardia lamblia
cyst in stool smear
Giardiosis
Fecal/oral transmission

in human vaginal smear
vaginal irritation
worldwide
Trichomonas vaginalis
trophozoite (only form) in vaginal smear
Trichomonasis
direct sexual contact

in human stool
diarrhea, fatigue, straining pain
worldwide
Entamoeba histolytica
trophozoite in feces
Amebiasis or Amebic Dysentery
fecal/oral transmission

in human stool
diarrhea, fatigue, straining pain
worldwide
Entamoeba histolytica
cyst in feces
Amebiasis or Amebic Dysentery
fecal/oral transmission

in human stool
no symptoms
worldwide
Entamoeba coli
trophozoite in feces
(commensal)
fecal/oral transmission

in human stool
no symptoms
worldwide
Entamoeba coli
cyst in feces
(commensal)
fecal/oral transmission
in humans and primates/birds
fever, regular synchronous paroxysms, coma, convulsions
SE Asia, South America, Africa
Plasmodium falciparum
trophozoites/schizonts and gametocyte (bananna)
Malaria
Mosquito (definitive host)

in human and primate/bird
fever, regular synchronous paroxysms, coma, convulsions
SE Asia, South America, Africa
Plasmodium falciparum
trophozoite/schizont
Malaria
Mosquito (definitive host)
in human
fever, regular synchronous paroxysms
SE Asia, South America, North Africa
Plasmodium vivax
trophozoite/schizont
Malaria
Mosquito (definitive host)
in human
fever, regular synchronous paroxysms
SE Asia, South America, North Africa
Plasmodium vivax
gametocyte (female macrogametocyte on left, male microgametocyte on right)
Malaria
Mosquito (definitive host)

in human and animal stool
abdomen cramps, diarrhea, anorexia
worldwide, common in tropics, outbreaks in North America
history of eating stawrberriy
Cyclospora cayetanensis
oocyst in feces
Cyclosporiasis
fecal/oral transmission

in human and animal stool
abdomen pain, diarrhea, anorexia
worldwide, common in tropics, outbreaks in North America
history of eating stawrberriy
Cyclospora cayetanensis
oocyst in feces
Cyclosporiasis
fecal/oral transmission

in human and animal stool
abdominal pain, diarrhea, dehydration
worldwide
Cryptosporidium parvum
oocyst in feces
Cryptosporidosis
fecal/oral transmission

in human and animal stool
abdominal pain, diarrhea, dehydration
worldwide
Cryptosporidium parvum
oocyst in feces
Cryptosporidosis
fecal/oral transmission

in abdominal fluid from cats
cerebral calcification, muscle aches in humans
worldwide
Toxoplasma gondii
tachyzoite in brain or abdominal fluid
Toxoplasmosis
fecal/oral transmission

in humans or cats
fever, muscle aches
worldwide
Toxoplasma gondii
brachyzoite cyst
Toxoplasmosis
fecal/oral transmission

in human urine
hematuria, cercarial dermatitis, eosinophilia
history of long term water exposure
Africa, Middle East
Schistosoma haematobium
egg
Urogenital Schistosomiasis
fecal/oral/cutaneous transmission

in human tissue section
cercarial dermatitis, eosinophilia
history of long term water exposure
Africa, Middle East, South America, Caribbean, East Asia, Asia Pacific
Schistosoma spp
adult male and female in copula
Schistosomiasis
fecal/oral/cutaneous transmission

in human blood vessels
cercarial dermatitis, eosinophilia
history of long term water exposure
Africa, Middle East, South America, Caribbean, East Asia, Asia Pacific
Schistosoma spp
adult male and female in copula
Schistosomiasis
fecal/oral/cutaneous transmission

in human stool
cercarial dermatitis, eosinophilia
history of long term water exposure
Africa, South America, Caribbean
Schistosoma mansoni
egg
schistosomiasis (intestinal and hepatic)
fecal/oral/cutaneous transmission

in human stool
cercarial dermatitis, eosinophilia
history of long term water exposure
East Asia, Pacific Asia
Schistosoma japonicum
egg
schistosomiasis (intestinal and hepatic)
fecal/oral/cutaneous transmission

in human or ruminant stool
liver fibrosis, blacks disease for cows/sheep
history of eating raw aquatic plants
worldwide
Fasciola hepatica
egg
Fascioliasis
aquatic plant ingestion

in human or ruminant
liver fibrosis, blacks disease for cows/sheep
history of eating raw aquatic plants
worldwide
Fasciola hepatica
adult liver fluke
Fascioliasis
aquatic plant ingestion

in human or dog/cat/carnivore stool
fibrosis, gall bladder inflammation, pancreatitis
history of eating raw freshwater fish
East Asia, East Russia, Indian Subcontinent, Pacific Asia
Clonorchis sinensis
egg
Clonorchiasis
eating raw freshwater fish

in human or dog/cat/carnivore
fibrosis, gall bladder inflammation, pancreatitis
history of eating raw freshwater fish
East Asia, East Russia, Indian Subcontinent, Pacific Asia
Clonorchis sinensis
adult liver fluke
Clonorchiasis
eating raw freshwater fish

in human, dog, pig, feline, carnivore stool
lung fibrosis, seizures, secondary pneumonia
history of eating raw/pickled crustaceans
East Asia, Africa, East Russia, Indian Subcontinent, Pacific Asia, Americas
Paragonimus westermani
egg
Paragonomiasis
eating raw/pickled crustaceans

in human, dog, pig, feline, carnivore
lung fibrosis, seizures, secondary pneumonia
history of eating raw/pickled crustaceans
East Asia, Africa, East Russia, Indian Subcontinent, Pacific Asia, Americas
Paragonimus westermani
adult lung fluke
Paragonomiasis
eating raw/pickled crustaceans

in human stool
epigastric pain, diarrhea, intestinal obstruction, proglottid passage, nutritional defieciencies
history of eating undercooked pork/beef
worldwide (endemic in C/S America, E Europe, S Asia, India, Africa)
Taenia spp
egg
Taeneasis
eating raw/undercooked pork or beef (T. solium or T. saginata)

in human
epigastric pain, diarrhea, intestinal obstruction, proglottid passage
history of eating undercooked pork
worldwide (endemic in C/S America, E Europe, S Asia, India, Africa)
Taenia solium
adult scolex with 4 acetabula and a rostellum
Taeneasis
eating raw/undercooked pork

in human
epigastric pain, diarrhea, intestinal obstruction, proglottid passage
history of eating undercooked pork/beef
worldwide (endemic in C/S America, E Europe, S Asia, India, Africa)
Taenia spp
adult worm with 1 lateral genital pore
Taeneasis
eating raw/undercooked pork or beef (T. solium or T. saginata)

in human
epigastric pain, diarrhea, intestinal obstruction, proglottid passage (in cow: heart faliure, beef measles)
history of eating undercooked beef
worldwide (endemic in C/S America, Africa)
Taenia saginata
adult scolex with 4 acetabula
Taeneasis
eating raw/undercooked beef

in human stool, fish, copepod
anemia, intestinal obstruction, bile duct inflammation, or asymptomatic
history of eating raw fish
worldwide (endemic in Scandanavia, Baltic area, Russia, America)
Diphyllobothrium latum
egg
Diphyllobothriasis
food born

in human
anemia, intestinal obstruction, bile duct inflammation, or asymptomatic
history of eating raw fish
worldwide (endemic in Scandanavia, Baltic area, Russia, America)
Diphyllobothrium latum
adult with central genital pore
Diphyllobothriasis
food born

in human
anemia, intestinal obstruction, bile duct inflammation, or asymptomatic
history of eating raw fish
worldwide (endemic in Scandanavia, Baltic area, Russia, America)
Diphyllobothrium latum
adult scolex with 2 bothria
Diphyllobothriasis
food born

in canine
ruminant, or human tissue, symptoms depend on ____ location/size (can include bone necrosis, organ problems, anaphylactic shock)
South CA, UT, Africa, Eruope, Eurasia, C/S America
Echinococcus granulosis
hydatid cyst
Echinococcosis (or unilocular hydatid)
food born

in canines
ruminants, humans, symptoms depend on ____ location/size (can include bone necrosis, organ problems, anaphylactic shock)
South CA, UT, Africa, Eruope, Eurasia, C/S America
Echinococcus granulosis
adult tapeworm (with 1 lateral genital pore)
Echinococcosis (or unilocular hydatid)
food born

in human
cat, dog stool, intestinal discomfort, proglottids crawl from anus
Worldwide (human infections in Europe, China, Pacific Asia, America
Dipylidium caninum
egg packet
Dipylidiasis
flea vector carrying cysticercoid

in human
cat, dog stool, intestinal discomfort, proglottids crawl from anus
Worldwide (human infections in Europe, China, Pacific Asia, America
Dipylidium caninum
adult with 2 lateral genital pores
Dipylidiasis
flea vector carrying cysticercoid

zoonotic, in dogs, small animals, human feces
dermatitis, anemia, respiratory damage
tropic/subtropics, warm regions
Ancylostoma caninum
infectious L3 larva
Ancylostomiasis
fecal/oral transmission

zoonotic, in dogs, small animals, human feces
dermatitis, anemia, respiratory damage
tropic/subtropics, warm regions
Ancylostoma caninum
egg (with morula)
Ancylostomiasis
fecal/oral transmission

in human feces
Dermatitis, coughing, lung hemorrhage, capillary hemorrhage, rarely kills
worldwide
Ancylostoma duodenale
infectious L3 larva
Ancylostomiasis
fecal/oral transmission

in human feces
Dermatitis, coughing, lung hemorrhage, capillary hemorrhage, rarely kills
worldwide
Ancylostoma duodenale
egg
Ancylostomiasis
fecal/oral transmission

in human feces
Dermatitis, coughing, lung/capillary hemorrhage, anemia, diarrhea
worldwide, tropic/subtropic regions, Africa, America, Asia
Necator americanus
infectious L3 larva
Necatoriasis
percutaneous (most common)

in human feces
Dermatitis, coughing, lung/capillary hemorrhage, anemia, diarrhea
worldwide, tropic/subtropic regions, Africa, America, Asia
Necator americanus
egg (with morula)
Necatoriasis
percutaneous (most common)

in dogs, cats, mammals, primates, human stool
dermatitis, pneumonia, eosinophilia, sepsis, death
worldwide, tropic/subtropics, south US
Strongyloides stercoralis
infectious L3 larva
Strongyloidiasis
percutaneous (most cases)

in dogs, cats, mammals, primates, human stool
dermatitis, pneumonia, eosinophilia, sepsis, death
worldwide, tropic/subtropics, south US
Strongyloides stercoralis
egg
Strongyloidiasis
percutaneous (most cases)

in humans and pigs
coughing, abdominal pian, intestinal obstruction, death
worldwide
Ascaris lumbricoides
egg
Ascariasis
fecal/oral transmission

in humans and pigs
coughing, abdominal pian, intestinal obstruction, death
worldwide
Ascaris lumbricoides
adult
Ascariasis
fecal/oral transmission

in human blood
lymphedemia
tropic/subtropics of Asia, Africa, Western Pacific, Caribbean, South America
Wucheria bancrofti
microfilariae
Lymphatic filariasis aka Elephantitis
mosquito vector

in human blood
calabar swelling, eye worm
West, Central Africa
Loa loa
microfilariae
Loiasis
deer fly vector

in wide range of hosts, human feces
Eosinophila, muscle pain, ocular pain, pneumonia, petechial hemorrhage in conjunctiva and under nail beds
worldwide
history of eating undercooked/raw meat
Trichinella spiralis
larva
Trichinellosis
ingestion of encysted larva in undercooked/raw meat

in wide range of hosts, human tissue
Eosinophila, muscle pain, ocular pain, pneumonia, petechial hemorrhage in conjunctiva and under nail beds
worldwide
history of eating undercooked/raw meat
Trichinella spiralis
encysted larva
Trichinellosis
ingestion of encysted larva in undercooked/raw meat

in human stool
cecal mucosa inflammation, catarrhal enteritis, rectal prolapse, growth retardation, bloody/mucoid diarrhea
worldwide (common in tropics)
Trichuris trichiura
adult
Trichuriasis
ingestion of eggs

in human stool
cecal mucosa inflammation, catarrhal enteritis, rectal prolapse, growth retardation, bloody/mucoid diarrhea
worldwide (common in tropics)
Trichuris trichiura
egg
Trichuriasis
ingestion of eggs

in human
red serpiginous tracks
Ancylostoma duodenale
adult hookworm

in human Knott’s test
Wucheraria or Loa
microfilaria

in human or young calf
calf with diarrhea or human with GI signs
from an acid fast test
Cryptosporidium parvum

in human
Cyclospora caetanensis

dog/cat ingests flea (or kid)
Dipylidium caninum

human suffering from severe diarrhea
use fine focus to count nuceli
Entomoeba histolytica
trophozoite (not fully spherical)

in human with GI problems
entamoeba histolytica
trophozoite

in humans with generic GI problems
Giardia lamblia
cyst

in humans with generic GI problems
Giardia lamblia

in human
Ancylostoma

in tissue section of human/animal
Leishmania
amastigotes
in human blood smear
Plasmodium falciparum
ring form
and crescent shaped gametocytes

blood in urine of human
Schistosoma haematobium

dioecious Schistosoma adults

from human stool
Schistosoma japonicum

from human stool
Schistosoma mansoni

in human
South America
Trypanosoma cruzi
with prominent kinetoplast

in fly vector
Trypanosoma
epimastigotes

fecal sample from human
Taenia
eggs (small, uniform, thick shell)

abdominal fluid
Toxoplasma gondii
tachyzoites

brain sample
Toxoplasma gondii
bradyzoites walled off in brain

in fecal sample
Trichuris trichura
eggs

larva found in Baermann funnel
Uncinaria
L3